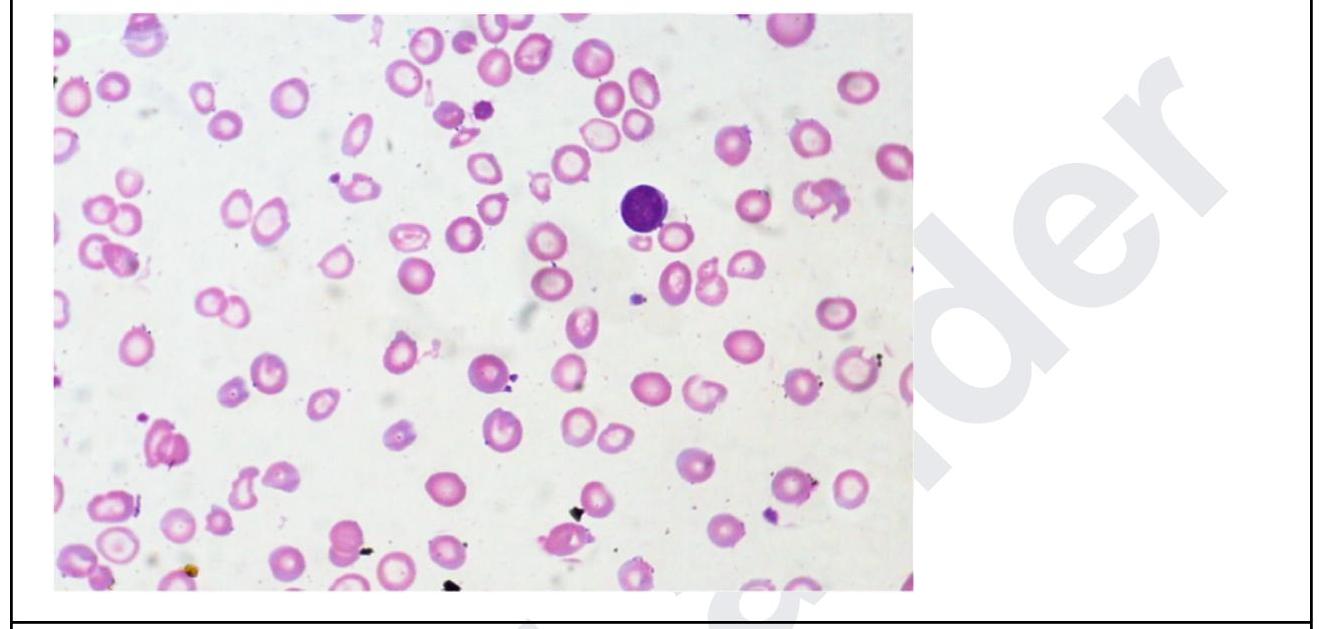
Image for question 4

Enter your email to get your 85% OFF code and unlock the full NEET PG question bank on the app.
Which of the following is a feature of Vit B12 deficiency anemia?
Which parameter is primarily used to diagnose macrocytosis in a complete blood count (CBC)?
Earliest manifestation of megaloblastic anemia is
A 35 year old woman presents with fatigue. Investigations revealed the following: Hb, 5 g/dL; MCH, 24; low MCV; leukocytes, 11,000/ uL, and platelets, 5 lakhs. The peripheral smear is shown below. What is the diagnosis? Normal values: - Mean cell volume (MCV); 90 ± 8 fL - Mean cell Hb(MCH); 30 ± 3 pg
Anemia with reticulocytosis is seen in -
A patient has MCV <80, MCH <23. Which type of anaemia shall be classified?
What is a known complication of Parvovirus B19 infection?
Which of the following is not likely to be seen in a patient with Paroxysmal Nocturnal Hemoglobinuria (PNH)?
Bleeding crisis in acute idiopathic thrombo-cytopenic purpura is managed by all except -
A 40-year-old presents with cirrhosis and low ferritin. What is the next step in management?
Get full access to all questions, explanations, and performance tracking.
Scan to download app